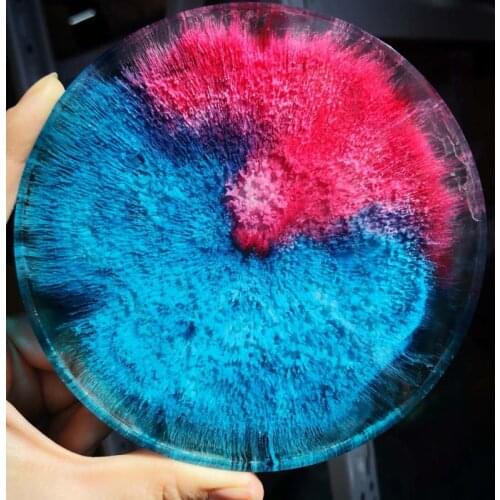
10ML Epoxy Resin Pigment Liquid Colorant Dye Ink Diffusion Resin Jewelry Making 1XCA

JAVRICK jewelery Tools buy at Shop910982014 Store
54 Jewelery Tools By JAVRICK Brand Found. Average value products in Jewelery Tools rubric: $4. JAVRICK brand goods are 26% more cheaper than others.
Price: $2.84
Old Price: $5.69Shop910982014 Store
Price: $8.5
Old Price: $17.01Shop910982014 Store
Price: $3.01
Shop910982014 Store
Price: $9.92
Old Price: $20.25Shop910982014 Store
Price: $7.67
Old Price: $15.35Shop910982014 Store
Price: $3.89
Old Price: $7.79Shop910982014 Store
Price: $8.28
Old Price: $16.57Shop910982014 Store
Price: $3.07
Old Price: $6.15Shop910982014 Store
Price: $9.92
Old Price: $19.84Shop910982014 Store
Price: $1.82
Old Price: $3.65Shop910982014 Store
Price: $2.44
Old Price: $4.88Shop910982014 Store
Price: $3.02
Old Price: $6.05Shop910982014 Store
Price: $1.18
Old Price: $2.37Shop910982014 Store
Price: $3.43
Old Price: $6.86Shop910982014 Store
Price: $1.52
Old Price: $3.04Shop910982014 Store
Price: $1.86
Old Price: $3.73Shop910982014 Store
Price: $0.86
Shop910982014 Store
Price: $1.63
Old Price: $3.27Shop910982014 Store
Price: $13.97
Shop910982014 Store
Price: $15.5
Old Price: $31.01Shop910982014 Store
Price: $1.26
Old Price: $2.52Shop910982014 Store
Price: $1.58
Old Price: $3.17Shop910982014 Store
Price: $75.08
Shop910982014 Store
Price: $1.44
Old Price: $2.88Shop910982014 Store
Price: $13.14
Old Price: $26.28Shop910982014 Store
Price: $1.54
Old Price: $3.08Shop910982014 Store
Price: $4.05
Old Price: $8.11Shop910982014 Store
Price: $15.3
Shop910982014 Store
Price: $36.53
Old Price: $73.06Shop910982014 Store
Price: $1.25
Old Price: $2.5Shop910982014 Store
Price: $3.71
Old Price: $7.43Shop910982014 Store
Price: $1.69
Old Price: $3.39Shop910982014 Store
Price: $11.19
Old Price: $22.39Shop910982014 Store
Price: $3.94
Old Price: $8.03Shop910982014 Store
Price: $13.34
Old Price: $26.69Shop910982014 Store
Price: $3.69
Old Price: $7.39Shop910982014 Store
Price: $1.52
Shop910982014 Store
Price: $9.11
Old Price: $18.61Shop910982014 Store
Price: $2.5
Old Price: $5.01Shop910982014 Store
Price: $1.37
Old Price: $2.74Shop910982014 Store
Price: $2.45
Old Price: $4.9Shop910982014 Store
Price: $1.01
Old Price: $2.02Shop910982014 Store
Price: $1.31
Old Price: $2.67Shop910982014 Store
Price: $2.78
Old Price: $5.57Shop910982014 Store
Price: $17.23
Old Price: $34.46Shop910982014 Store
Price: $8.65
Old Price: $17.3Shop910982014 Store
Price: $1.03
Old Price: $2.06Shop910982014 Store
Price: $11.98
Shop910982014 Store
Price: $4.2
Shop910982014 Store
Price: $8.74
Old Price: $17.48Shop910982014 Store
Price: $1.86
Old Price: $3.72Shop910982014 Store
Price: $2.5
Old Price: $5Shop910982014 Store